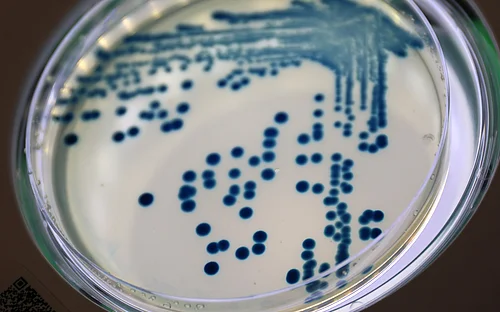
Wenn Resistenz mit Virulenz einhergeht

Helmholtz-Institut für One Health (HIOH)

Das Helmholtz-Institut für One Health (HIOH) in Greifswald wurde 2021 als Außen-Standort des Helmholtz-Zentrums für Infektionsforschung (HZI) gegründet. In enger Zusammenarbeit mit seinen lokalen Gründungspartnern: der Universität Greifswald, der Universitätsmedizin Greifswald und dem Friedrich- Loeffler-Institut (Bundesforschungsinstitut für Tiergesundheit Greifswald- Riems) widmet sich das HIOH der interdisziplinären Erforschung der Zusammenhänge zwischen Mensch-, Tier- und Umweltgesundheit. Unser Ziel ist ein besseres Verständnis zoonotischer Erkrankungen, antimikrobieller Resistenzen und der Evolution von Pathogenen als Voraussetzung für erfolgreiche Pandemievorsorge und –prävention.
Über den Standort










Das Helmholtz-Institut für One Health (HIOH) in Greifswald ist ein neues Institut des Helmholtz-Zentrums für Infektionsforschung (HZI). Das Institut ist eng vernetzt mit seinen lokalen Gründungspartnern: der Universität Greifswald, der Universitätsmedizin Greifswald und dem Friedrich-Loeffler-Institut. Das HIOH befasst sich mit der Bedrohung durch das Auftreten neuartiger Krankheitserreger sowie mit der Veränderung bekannter Krankheitserreger, einschließlich deren antimikrobieller Resistenzen (AMR). Das Institut verfolgt dabei einen umfassenden Forschungsansatz, der auch integrierte Überwachung und Verbesserung der Gesundheit von Mensch und Tier sowie von Umwelt- und Klimafaktoren umfasst.
Die derzeitige Weltbevölkerung von etwa 8 Milliarden Menschen wird den Prognosen zufolge bis zum Jahr 2100 auf über 11 Milliarden anwachsen. Aufgrund des weltweit zunehmenden anthropogenen Einflusses verändert sich das Klima, der Kontakt zwischen Mensch und Tier wird intensiver und immer mehr Wildnis wird in Ackerland umgewandelt. Zusammengenommen führen diese Veränderungen zu einem erhöhten Risiko für die Übertragung von Zoonosen aus der großen mikrobiellen Vielfalt in Wildtieren und der Umwelt auf den Menschen. Durch die Globalisierung können sich lokal auftretende Krankheitserreger rasch weltweit ausbreiten, wie kürzlich bei der COVID-19-Pandemie zu beobachten war. Die rasche Entwicklung von Resistenzen gegen Impfstoffe und Therapeutika verschärft die von Zoonosen ausgehende Bedrohung weiter. Dies bedeutet, dass die globale menschliche Gesundheit ein Produkt der Interaktionen des Menschen mit Tieren und der Umwelt ist. Daher werden isolierte Ansätze, die sich auf die Gesundheit von Mensch oder Tier konzentrieren, nicht ausreichen, um die Entstehung von Krankheiten zu verstehen und die Entwicklung von Präventivmaßnahmen zu verhindern. Integrative transdisziplinäre Ansätze, die im Rahmen eines One Health Konzepts arbeiten, d. h. eines ganzheitlichen Ansatzes, der sich auf die Gesundheit von Menschen und Tieren in ihrer Umwelt konzentriert, sind eindeutig erforderlich, um diese komplexen, vielschichtigen Probleme zu bewältigen.
Das Forschungskonzept
Das Helmholtz- Institut für One Health verfolgt einen solchen interdisziplinären Ansatz. Der Schwerpunkt dieses neuen Standorts des HZI liegt auf der Untersuchung der Schnittstellen zwischen der Gesundheit von Mensch, Tier und Umwelt durch longitudinale und umfassende Probenahmen, Datenerhebungen und -analysen in Bezug auf neu auftretende Infektionen/Mikroorganismen und Resistenzen in zwei Modellregionen. Einer der Forschungsschwerpunkte befasst sich mit den afrikanischen Tropen, da dieses Gebiet ein Hotspot für das Auftreten von Krankheiten und antimikrobiellen Resistenzen ist. Das andere Schwerpunktgebiet liegt direkt vor der Haustür des HIOH in Mecklenburg- Vorpommern. Die Studien in den Schwerpunktgebieten werden durch drittmittelfinanzierte weitere und globale Studien in zusätzlichen Hochrisikogebieten, wie z.B. Asien, komplementiert. Das HIOH generiert, analysiert und integriert umfassende longitudinale Gesundheitsdaten als auch Daten über Krankheitserreger an den Schnittstellen zwischen Mensch und Tier.
Diese Tätigkeiten werden durch die Einbettung des HIOH in das bestehende Netzwerk der international renommierten Gründungsinstitutionen maßgeblich gestärkt, durch das ein breites Spektrum von Schlüsseldisziplinen synergetisch eingebracht wird, insbesondere Human- und Veterinärmedizin, Mikrobiologie, Virologie, Epidemiologie, Arzneimittelforschung, Biodiversitätsforschung, Anthropologie, Soziologie, Evolutionsbiologie und Ökologie. Die Qualität, Quantität und Vielfalt der integrierten Daten, die das HIOH generiert, wird ein neues mechanistisches Verständnis dafür ermöglichen, welche Störungen durch Veränderungen einzelner Parameter hervorgerufen werden, und damit Chancen eröffnen, die Ausbreitung gefährlicher Mikroben in Zukunft besser zu kontrollieren. Die drei Forschungsabteilungen beschäftigen sich mit (1) Ökologie und Entstehung von Zoonosen, (2) Epidemiologie und Ökologie antimikrobieller Resistenz und (3) Pathogen- Evolution. Zwei Core Units und zukünftig eine Nachwuchsgruppe ergänzen diese Abteilungen und bieten zusätzlichen Raum für weitere innovative und translationale Ansätze.
Mit seinem integrierten und zeitgemäßen wissenschaftlichen Konzept, einem einzigartigen Cluster von komplementären Gründungspartnern und einer hochmodernen Infrastruktur in Greifswald bietet das HIOH ein lebendiges Forschungsumfeld für deutsche und internationale Wissenschaftler:innen, um drängende globale Probleme anzugehen. Die Synergie zwischen dem HIOH und seinen Mutterinstitutionen fördert hochgradig integrative Forschung und deren Translation in die Prävention und Therapie von Infektionskrankheiten im Rahmen von One Health. Das HIOH und seine Partner leisten damit wichtige Beiträge zu einer verbesserten „Pandemic Preparedness“ und einer effektiveren Bekämpfung von antimikrobiellen Resistenzen im Rahmen des One Health Ansatzes.
Weitere Informationen:
Das Helmholtz-Zentrum für Infektionsforschung (HZI) hat in enger Kooperation mit der Universität Greifswald (UG), der Universitätsmedizin Greifswald (UMG) und dem Friedrich-Loeffler-Institut (FLI; Bundesforschungsinstitut für Tiergesundheit) das Helmholtz-Institut für One Health (HIOH) in Greifswald als Teil des HZI gegründet. Zudem arbeitete das HIOH mit verschiedensten Kooperationspartnern zusammen.
Detailliertere Informationen zu den Kooperationspartnern finden Sie unter https://www.helmholtz-hioh.de/de/kooperationen/